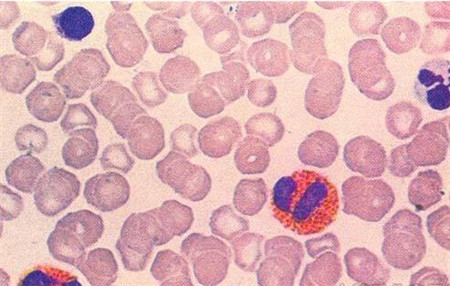
白血球高是怎么回事

白血球高是怎么回事
450x286 - 51KB - JPEG

伤口上的纱布,凝结了红血球的棉纤维 ,伤口上的
440x417 - 59KB - JPEG

治疗与血球系统_《暗黑破坏神3》专区
270x247 - 94KB - PNG

血细胞图片_血细胞素材_血细胞模板免费下载
265x265 - 23KB - JPEG
这个神奇的浴场--让离体的血细胞欢呼雀跃 - 今
500x483 - 19KB - JPEG

血细胞图片_血细胞素材_血细胞模板免费下载
265x346 - 35KB - JPEG

暗黑三血球制作|UI|图标|WorldKing - 原创作品
1280x727 - 381KB - PNG

(附PSD下载)三色血球|移动设备主题\/APP皮肤
900x900 - 246KB - JPEG

卫生部血细胞形态学室间质量评价及答案(2015
640x493 - 23KB - JPEG

血细胞设计图__广告设计_广告设计_设计图库
1024x647 - 296KB - JPEG

红细胞,红血球,人体静脉,人体静脉血管
1200x800 - 430KB - JPEG

红细胞,红血球,血细胞,造血细胞
1200x1200 - 732KB - JPEG

急性肾小管坏死(图)血细胞
361x478 - 95KB - JPEG

白血病血细胞。彩色扫描电子显微镜sem的血液
1280x1142 - 437KB - JPEG

血球计数器价格_血球计数器批发_血球计数器
1239x1280 - 198KB - JPEG